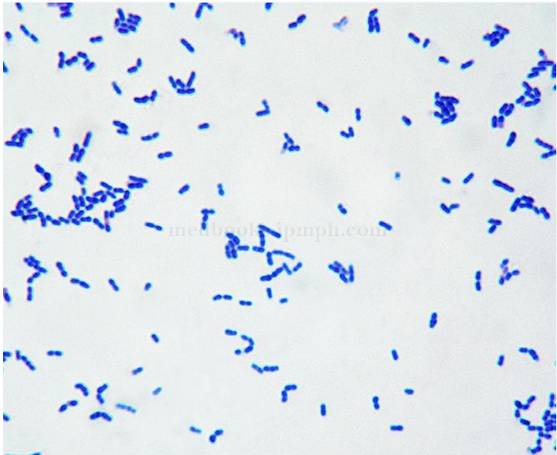
29周胎儿胎死腹中什么原因,28周胎死腹中的原因

前些日子,杭州市临安区妇幼保健计生服务中心接诊了一位28周的准妈妈,她突然出现高热、寒战、肌肉酸痛、腹泻,测体温39.3°C,胎心200次/分钟。医生立即让她去住院治疗。
第二天回访,得到了一个悲伤的消息:28周的胎儿已娩出,是死胎。
五天后,病理检查结果出来了,胎盘中分离出“李斯特菌”。
而这一切,源于她前几天喝了一口牛奶,之前已开封没喝完,放在了冰箱中。

医生手绘“李斯特菌”
事实上,“李斯特菌”这个“凶手”一点也不陌生。
今年4月,杭州一位二孩孕妈阿霞由于吃了冰箱里的剩菜,以及一盘凉拌海带,感染了一种被称为“冰箱杀手”的细菌——李斯特菌,两三天后,她出现了发热、全身乏力症状,险些胎死腹中。

所幸,在经过鉴定确诊为单核李斯特菌增生感染后,医生为阿霞和宝宝使用了针对性的抗菌治疗。经过各方积极治疗,阿霞的宝宝各项指标有所好转,最终出院。
单核李斯特菌究竟是什么?
李斯特菌在环境中无处不在,绝大多数食品中均能找到。肉类(尤其是牛肉)、蛋类、禽类、海产品、乳制品、蔬菜、冰激凌等,都已被证实是李斯特菌的感染源。

国家食药总局发布风险提示:李斯特菌已成为威胁食品安全的重要因素。被李斯特菌感染的人,有64%可以在家中的冰箱找到这种细菌。李斯特菌不易被冻融,能耐受较高的渗透压,可以在-1~45°内存活和生长,一些特别耐寒冷的菌株,冰箱的-18°都冻不死它。
李斯特菌显微镜下形态
李斯特菌虽然毒性很强,但致病力并不十分高,可以说它是看人下菜碟的,对于健康成年人,即使感染了这种细菌,一般不会造成严重后果,甚至携带病菌也不会发病。
但是它喜欢欺负孕妇、胎儿、婴儿、老人以及免疫力低下人群,日常生活中,孕妇的感染概率是普通人的20倍左右,而且感染后的症状会比一般人更严重,感染该细菌的孕妇流产的比例约在30%左右,新生儿(早产儿)的症状多为败血症、脑膜炎,死亡率高达30%-70%。
看到这里
准妈妈们也不必太过惊慌
只要做到以下这几点
就可以很大程度上的避免李斯特菌病从口入
如何对付李斯特菌?
李斯特菌虽然耐冷耐盐耐碱,危害巨大,看上去很难对付,但它不耐热!70°以上加热两分钟以上就可以消灭李斯特菌。这样一来,事情就变得简单了。我们只要确保食物已充分加热,就可以杀死李斯特菌。
预防李斯特菌,注意这十点
1.加工食物前要洗手。
2.刀和砧板要洗净晾干。
3.生熟分开保存。
4.不吃未经巴氏消毒的乳制品。
5.乳制品尽量不要买大包装,避免一次性吃不完要放入冰箱保存。
6.冰箱里存放的饭菜食用前要充分加热。
7.孕妇、幼儿、老人及抵抗力低下者尽量不要吃冰激凌,因为冰激凌没法加热。
8.定期清理冰箱,食物在冰箱中冷藏尽量不要超过三天。

9.如果出现上吐下泻,畏寒发热等症状,请及时去医院就诊。
10.尽量避免去卫生条件不好的餐馆。

使用冰箱还应该注意:
1.食物摆放有讲究

冰箱内存放的食品一定要生熟分开,防止交叉污染,食用前应检查食品质量。从冰箱里往外取食物时,用多少取多少,不要用不完又放进去。冰箱里存放食物不要太多,东西之间应有空隙,若是大件大块的食品,应切开后存放。
2.冷食不宜马上吃

冰箱内取出的、不能再加热的食品,宜在室温下放置一段时间后再食用。冰箱里的冷饮、冷食,天气再热,也不要拿出来就吃,更不要在大汗淋漓、口渴难忍时过量食用。
3.存放时间有限制
掌握不同食品的存放时间,选择适当的存放区。冰箱存放食物的时间不宜过长,肉类生品冷藏时间一般不宜超过2天,瓜果蔬菜不宜超过5天。为了不使冷藏食品存放超过规定时间,最好在冰箱外面挂上一个本子,以便记录存放时间。
常见蔬菜冷藏和冷冻时间周期推荐↓↓

4.食物入箱前别清洗

很多朋友习惯将食物清洗,甚至用杀菌洗涤剂清洗后再放入冰箱,其实,蔬果肉蛋表面有着自己的一层防菌“保护膜”,将保护膜洗掉后,反而有助于细菌入侵食物,加速食物腐败变质。
如果发现蔬果、鸡蛋等表皮有脏物,可以用布擦拭后,套上保鲜袋再放入冰箱。
5.不宜放入冰箱冷藏的食物

黄瓜、青椒、茄子等蔬菜在冰箱中久存,会出现“冻伤”,变黑、变软、变味。
香蕉、火龙果、芒果、荔枝、龙眼、木瓜、红毛丹等热带水果也不宜冷藏,否则果肉会变黑和变味。
土豆、红薯、萝卜等,因其表皮比较厚实,一般不容易腐烂,不用放入冰箱储存,存放于室内阴凉干燥处即可。
6.夏季冰箱常清洗

夏季一般建议每周或每月对电冰箱清洗一次。冰箱内部可用硼酸或消毒纸巾来擦拭,有助于除霜。冰箱内部的滴水槽、隔板槽等死角可进行喷射消毒剂消毒,冰箱内部与层板,可用稀释的漂白水擦拭,既干净又可达到杀菌的功效。
冰箱的门垫特别是门垫的凹槽,可用旧牙刷蘸上洗洁精擦拭,再用干布擦干,冰箱面板的污垢可用牙膏来清除。

猜你喜欢

长沙已开通16条社区巴士(附线路图),包括万科魅力之城
紧急提醒!长株潭交警正联手查酒驾(视频)
杨家山社区起火,又是电动车惹祸!
来源丨都市快报、新华每日电讯、央视新闻、新华网
编辑丨刘树源
值班主任丨黄慧莹

点亮

,让更多人看到!